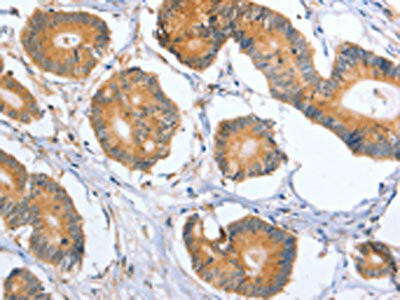
BLNK Antibody (PACO19352)

Description
BLNK Antibody (PACO19352)
The BLNK Antibody (PAC019352) is a valuable tool for researchers studying B-cell receptor signaling pathways. BLNK, also known as B-Cell Linker Protein, plays a crucial role in transducing signals from the B-cell receptor to downstream signaling molecules, ultimately leading to cellular responses such as proliferation and differentiation.This polyclonal antibody is raised in rabbits and has been validated for use in Western blot applications, where it specifically binds to BLNK protein. It is highly reactive with human samples, making it ideal for studying B-cell signaling in immunology and cancer research.
Understanding the function of BLNK is essential for unraveling the complexities of B-cell receptor signaling and its implications in diseases such as leukemia, lymphoma, and autoimmune disorders. The BLNK Antibody provides researchers with a reliable tool to investigate the role of BLNK in these pathways, paving the way for potential therapeutic interventions targeting B-cell signaling.
| Antibody Name: | BLNK Antibody (PACO19352) |
| Antibody SKU: | PACO19352 |
| Size: | 50ul |
| Host Species: | Rabbit |
| Tested Applications: | ELISA, WB, IHC |
| Recommended Dilutions: | ELISA:1:2000-1:5000, WB:1:500-1:2000, IHC:1:50-1:200 |
| Species Reactivity: | Human, Mouse, Rat |
| Immunogen: | Synthetic peptide of human BLNK |
| Form: | Liquid |
| Storage Buffer: | -20°C, pH7.4 PBS, 0.05% NaN3, 40% Glycerol |
| Purification Method: | Antigen affinity purification |
| Clonality: | Polyclonal |
| Isotype: | IgG |
| Conjugate: | Non-conjugated |
 | The image on the left is immunohistochemistry of paraffin-embedded Human colon cancer tissue using PACO19352(BLNK Antibody) at dilution 1/50, on the right is treated with synthetic peptide. (Original magnification: x200). |
 | Gel: 8%SDS-PAGE, Lysate: 40 μg, Lane 1-3: Mouse liver, Mouse kidney tissue, Mouse pancreas tissue, Primary antibody: PACO19352(BLNK Antibody) at dilution 1/550, Secondary antibody: Goat anti rabbit IgG at 1/8000 dilution, Exposure time: 40 seconds. |
 | The image on the left is immunohistochemistry of paraffin-embedded Human lung cancer tissue using PACO19352(BLNK Antibody) at dilution 1/50, on the right is treated with synthetic peptide. (Original magnification: x200). |
| Background: | This gene encodes a cytoplasmic linker or adaptor protein that plays a critical role in B cell development. This protein bridges B cell receptor-associated kinase activation with downstream signaling pathways, thereby affecting various biological functions. The phosphorylation of five tyrosine residues is necessary for this protein to nucleate distinct signaling effectors following B cell receptor activation. Mutations in this gene cause hypoglobulinemia and absent B cells, a disease in which the pro- to pre-B-cell transition is developmentally blocked. Deficiency in this protein has also been shown in some cases of pre-B acute lymphoblastic leukemia. |
| Synonyms: | B-cell linker |
| UniProt Protein Function: | BLNK: an adaptor protein that bridges the B-cell receptor-associated kinases (BCR) with a multitude of signaling pathways, regulating biologic outcomes of B-cell function and development. Plays an important role in BCR-mediated PLCG1 activation and Ca(2 ) mobilization. Does not seem to be not required for pre-BCR-mediated activation of MAP kinase and phosphatidyl-inositol 3 (PI3) kinase signaling. Plays a critical role in orchestrating the pro-B cell to pre-B cell transition. Following BCR activation, phosphorylated on tyrosine residues by SYK and LYN. When phosphorylated, serves as a scaffold to assemble downstream targets of antigen activation, including PLCG1, VAV1, GRB2 and NCK1. Its phosphorylation is required for both Ca(2 ) and MAPK signaling pathways. Defects in BLNK are the cause of hypoglobulinemia and absent B-cells.It has tumor supressor activity that is lost in many cases of childhood pre-B acute lymphoblastic leukemia (ALL). Two alternatively spliced isoforms have been described; these are differentially involved in activation and apoptosis of B lymphocytes. |
| UniProt Protein Details: | Protein type:Adaptor/scaffold Chromosomal Location of Human Ortholog: 10q23.2-q23.33 Cellular Component: cytoplasm; cytosol; plasma membrane Molecular Function:protein binding; SH3/SH2 adaptor activity; transmembrane receptor protein tyrosine kinase adaptor protein activity Biological Process: humoral immune response; inflammatory response Disease: Agammaglobulinemia 4, Autosomal Recessive |
| NCBI Summary: | This gene encodes a cytoplasmic linker or adaptor protein that plays a critical role in B cell development. This protein bridges B cell receptor-associated kinase activation with downstream signaling pathways, thereby affecting various biological functions. The phosphorylation of five tyrosine residues is necessary for this protein to nucleate distinct signaling effectors following B cell receptor activation. Mutations in this gene cause hypoglobulinemia and absent B cells, a disease in which the pro- to pre-B-cell transition is developmentally blocked. Deficiency in this protein has also been shown in some cases of pre-B acute lymphoblastic leukemia. Alternatively spliced transcript variants have been found for this gene. [provided by RefSeq, May 2012] |
| UniProt Code: | Q8WV28 |
| NCBI GenInfo Identifier: | 82592659 |
| NCBI Gene ID: | 29760 |
| NCBI Accession: | Q8WV28.2 |
| UniProt Secondary Accession: | Q8WV28,O75498, O75499, Q2MD49, |
| UniProt Related Accession: | Q8WV28 |
| Molecular Weight: | 44,451 Da |
| NCBI Full Name: | B-cell linker protein |
| NCBI Synonym Full Names: | B-cell linker |
| NCBI Official Symbol: | BLNK |
| NCBI Official Synonym Symbols: | bca; AGM4; BASH; LY57; SLP65; BLNK-S; SLP-65 |
| NCBI Protein Information: | B-cell linker protein |
| UniProt Protein Name: | B-cell linker protein |
| UniProt Synonym Protein Names: | B-cell adapter containing a SH2 domain protein; B-cell adapter containing a Src homology 2 domain protein; Cytoplasmic adapter protein; Src homology 2 domain-containing leukocyte protein of 65 kDa; SLP-65 |
| Protein Family: | B-cell linker protein |
| UniProt Gene Name: | BLNK |
| UniProt Entry Name: | BLNK_HUMAN |
| Secondary Antibody |
| Anti-HRP Goat Anti-Rabbit IgG (H+L) Antibody (CABS014) |
| Recommended Products |
| Anti-FITC Goat Anti-Rabbit IgG (H+L) Antibody (CABS011) |
| Anti-HRP-conjugated Beta Actin Antibody (CABC028) |